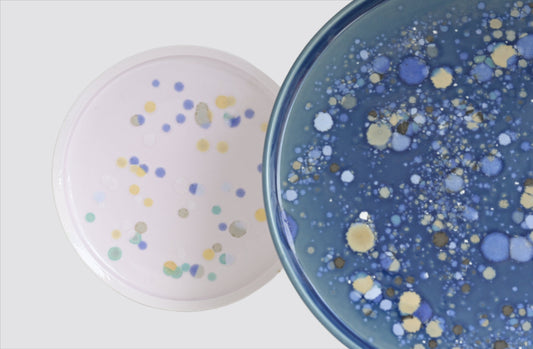
Culture Plate Blue by Attua Aparicio

Collection: GIFTS & CARDS
A curated selection of unique handmade works and souvenirs, perfect for gifting to friends & family, or a treat to yourself
-
Van Gogh Egg Cups (2025) by Alice Macdonald
Regular price £30.00 GBPRegular priceUnit price / perSale price £30.00 GBP -
Sold outSunflower by Karoline Rerrie
Regular price From £3.05 GBPRegular priceUnit price / perSale price From £3.05 GBPSold out -
Vintage Jug
Regular price £60.00 GBPRegular priceUnit price / perSale price £60.00 GBP -
Culture Plate Blue by Attua Aparicio
Regular price £80.00 GBPRegular priceUnit price / perSale price £80.00 GBP -
Candle Holders by Attua Aparicio
Regular price £70.00 GBPRegular priceUnit price / perSale price £70.00 GBP -
Culture Plate (White) by Attua Aparicio
Regular price £50.00 GBPRegular priceUnit price / per£80.00 GBPSale price £50.00 GBPSale -
Attua Aparicio: Vessles
Regular price £60.00 GBPRegular priceUnit price / perSale price £60.00 GBP -
Soleil by Roxane Mbanga
Regular price £2.50 GBPRegular priceUnit price / perSale price £2.50 GBP -
Terracotta watering roses by Camille Biddell
Regular price From £35.00 GBPRegular priceUnit price / perSale price From £35.00 GBP -
Guardian Candlestick by Camilla Bliss
Regular price £92.00 GBPRegular priceUnit price / perSale price £92.00 GBP -
Resin Conker necklace by Grace Richardson
Regular price £60.00 GBPRegular priceUnit price / perSale price £60.00 GBP -
Cups by Jake Fisk
Regular price £38.00 GBPRegular priceUnit price / perSale price £38.00 GBP